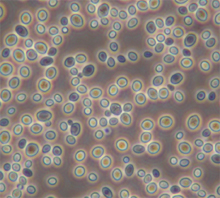
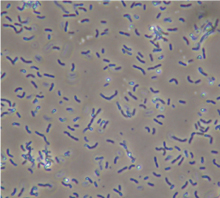

LOHAS material(ロハスマテリアル) 床下調湿材 EM床下ドライの説明

EM床下ドライとは・・・
◆ 基本の商品になります。コストを安く抑えたい方にオススメです。
珪藻頁岩と消石灰を混合した、自然素材100%の安心・安全な床下調湿材。
床下の湿気を珪藻頁岩が吸収し、適度な湿度に調整。
珪藻頁岩の吸湿・放湿効果で半永久的な調湿効果。
嫌なにおいも吸着し、消石灰で高い防カビ効果。
腐朽から床・壁・構造材をまもり、家を健康にする床下調湿材です。








| 吸放湿性 | 消臭効果 | 耐ウイルス 効果 |
防カビ効果 | 防虫効果 | 品質安全 | 持続性 | |
| EM床下 ドライ |
◎ 高い |
○ 得手・不得手がある |
◎ 高い |
◎ 高い |
◎ 高い |
○ 天然素材 |
○ 半永久的 |
| 炭類 | △ 吸った湿気を吐く力が弱い |
○ 得手・不得手がある |
△ 低い |
△ 低い |
△ 低い |
△ 可燃性 |
△ 持続不可 |
| ゼオライト | × 吸った湿気を吐く力が弱い |
○ 得手・不得手がある |
△ 低い |
△ 低い |
△ 低い |
○ 天然素材 |
△ 持続不可 |
「EM床下ドライ」は・・・
◆ 優れた吸放湿性と自発呼吸効果
◆ アンモニアやホルムアルデヒドを吸収し消臭効果
◆ 耐ウイルス・防カビ効果
◆ シロアリ・腐朽菌の繁殖を抑制
◆ 不燃性で安心・安全の自然素材100%
◆ 効果は半永久的
入れ替えや再散布の必要がなく、手間とコストが抑えられます!
※例:ベタ基礎の場合



■よくあるご質問
Q.土面に敷く防湿シートは、ビニールシート等でも問題ありませんか?
A.ビニールシートは、湿気を通してしまう可能性があります。防湿シート(ポリプロピレンシート等)をご使用ください。
A.ビニールシートは、湿気を通してしまう可能性があります。防湿シート(ポリプロピレンシート等)をご使用ください。
![]() |
EMは、「有用微生物群」の英語名「Effective Microorganisms」を略した造語です。有用微生物群とは、簡単に言うと、食品加工にも使われている乳酸菌や酵母菌などいわゆる善玉菌を何十種類も混ぜ合わせたものです。通常、微生物は単一種類で扱われるのが一般的ですが、EMでは複数の微生物を混ぜ合わせることにより、幅広い対象に有効に作用します。このEMには、生物を始めとしたあらゆる対象を分子レベルで蘇生(活性化)させる力があり、国内外で農業や医療、環境浄化、建築など多岐の分野で高く評価され活用されています。
OK-DEPOTでは、専門機関との連携により長年の研究を重ね、EMと珪藻土を融合し、独自の建築資材として実用化することに成功しました。
![]() | ![]() | ![]() |
||
| 酵母菌 | 光合成細菌 | 乳酸菌(ラクトバチルス) | ||
| 有機物を発酵する力が強く、菌体がビタミンやアミノ酸を多く含んでいます。 | EMの中心的な微生物で有害物質を浄化し、抗酸化物質を生成します。 乳酸菌や酵母と一緒になることでさらに活発に働きます。 | 有機物を発酵する力が強く、有機酸を生成し、病原菌の繁殖を抑制します。 |
※「EM床下ドライ」は、EM研究機構・EM研究所・EM生活との正式なライセンス契約に基づいて製造しています。
※電子顕微鏡による高倍率画像

■採用理由
築50年の古民家を一部改装する際に、床下に敷く調湿材を探していました。過去に白蟻被害もあったので、防蟻効果があり、かつ自然素材100%を探していて、
運良くこの商品に出会う事ができました。
■感想
先日この調湿材を使用したばかりなので、まだ効果を実感できていませんが、
特に湿気が多かった箇所の防湿効果や床下の構造材が長持ちするのを期待しています。
■その他
またDIYリフォームの機会があれば購入したいと思います。
こちらの商品の効果は薬剤と違い、半永久的に続きます。
効果の体感はこれからかと思いますが、ご期待頂ければ幸いです。さらに防蟻効果をご希望の場合には床下ドライSもございますのでご検討頂ければと思います。
今後ともよろしくお願い致します。
自宅の床をリフォームする際に大工さんに材料支給で施工してもらいました。
解体してみると床下に少々カビが出ていたようで、何か良いものが無いか?と探していた所、
なるべく自然素材で身体にも害がない物でと探して100%自然素材の御社の製品にたどり着きました。施工してくれた大工さんも「変なにおいもしなくて敷くだけだし良いね!」と言ってくれ快く施工してくれました。効果はこれからと思いますが、珪藻土の調湿効果に期待しています。
施工頂いた大工さんにもお褒め頂き嬉しく思います。
ご購入頂きましたEM床下ドライの効果としては
ご期待の防かび効果の他、調湿効果、消臭効果、防蟻効果もございます。
なお且つ効果は薬剤と違い、半永久的に続きます。
まさに縁の下の力持ちではございませんが、Big PAPAさまのお家を末長くお守りするお手伝いができると思います。
効果の体感はこれからかと思いますが、ご期待頂ければ幸いです。
今後ともよろしくお願い致します。
ありがとうございました。